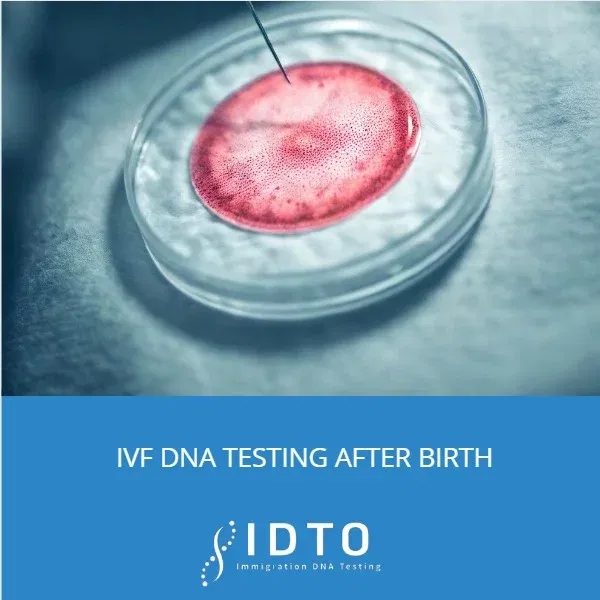
dna testing after in vitro

We recognize and understand the emotional toll that going through IVF in-vitro fertilization can take on both the soon-to-be mother and her partner or spouse.
Over the years, many fertility clinics have offered IVF to people who believe the process will be successful. Unfortunately, due to current standards in the United States, fertility clinics are not required to provide their failure statistics, yet they can advertise any level of success because there are no checks and balances in the protocol. In fact, the US has no mandatory reporting requirements for adverse IVF incidents, meaning errors can go undisclosed without consequence.
Consequently, true statistics not only in the U.S. but worldwide are very difficult to obtain and are produced and advertised primarily for the benefit of fertility clinics. Even in the United Kingdom, which has the most transparent reporting system in the world, only one to two serious incidents are officially recorded per year. In countries without mandated reporting, the true number of errors is widely believed to be significantly higher.
IVF mix-ups where embryos, sperm, or eggs are incorrectly identified or transferred are more common than many people realize. A 2023 case in Georgia involved a woman who delivered a baby that was genetically unrelated to her or her sperm donor, resulting in a custody battle that forced her to give up her five-month-old child.
In 2025, a woman in Brisbane, Australia, unknowingly gave birth to a baby belonging genetically to strangers described as unprecedented in Australia’s 40-year IVF history. Experts attribute these errors to human mistake, inadequate staffing, insufficient laboratory training, and high-pressure clinical environments.
For families who have concerns about their IVF procedure, a DNA relationship test between the mother and child, or the father and child, is strongly recommended. This test helps confirm that the fertility clinic performed the procedure correctly and that the right embryo was used. Given that most errors in unregulated markets go unreported, independent verification through DNA testing is one of the few ways families can protect themselves with certainty.
Are you looking to confirm a biological relationship after a possible IVF mix-up? Below is a brief overview of our services. For more information, contact our customer support team at 888-204-0583 one of our DNA consultants will be happy to assist you.
What type of DNA tests can be performed?
The commonly performed DNA tests used to prove confirm parent and child relationships for IVF mix-ups below.
Maternity Testing: This testing option determines a biological relationship between a woman and child.
Paternity Testing: This type of test helps to determine a biological relationship between a man and child.
How much does this legal maternity test cost for IVF purposes?
Pricing starts for legal maternity and paternity testing options start at $375.00 and up. See more our parental DNA Testing services here.
Where can I go schedule a legal DNA testing appointment?
Contact our customer support today at 888-204-0583 to schedule an appointment in a city near you today. IDTO currently has over 3,000 collection facilities in our network to schedule appointments in a city near you nationwide.
- Alabama
- Arizona
- Arkansas
- California
- Colorado
- Connecticut
- Delaware
- Florida
- Georgia
- Hawaii
- Idaho
- Illinois
- Indiana
- Iowa
- Kansas
- Kentucky
- Louisiana
- Maine
- Maryland
- Massachusetts
- Michigan
- Minnesota
- Mississippi
- Missouri
- Montana
- Nebraska
- Nevada
- New Hampshire
- New Jersey
- New Mexico
- New York
- North Carolina
- North Dakota
- Ohio
- Oklahoma
- Oregon
- Pennsylvania
- Rhode Island
- South Carolina
- Tennessee
- Texas
- Utah
- Vermont
- Virginia
- Washington
- West Virginia
- Wisconsin
Frequently Asked Questions
How long does it take to receive my DNA results?
The turnaround times for results is 2 to 3 business days from the date the lab receives all DNA samples.
Upon the completion of your results, a copy will be mailed to your home and an additional copy will be emailed to you.
Yes. All legal chain-of-custody DNA test results are legally admissible. Samples are tested and analyzed by our AABB-accredited partner laboratory, an accreditation required for results to be recognized in legal proceedings.
Legal DNA results are accepted for the following purposes:
- Court cases, including IVF disputes, child support, and child custody.
- Adding a parent’s name to a child’s birth certificate.
When should parents perform a DNA test after an IVF?
DNA testing is the recommended method to confirm that an IVF procedure was carried out correctly and that the right embryo was used.
We suggest testing shortly after the procedure, as early results make it easier to establish parental biological relationships, protect parental rights, and address any concerns with the clinic before records become harder to access. Acting promptly gives families the best chance to resolve any issues with minimal long-term impact.
How do IVF clinics respond to embryo mix-ups?
When an embryo mix-up is discovered, clinics are required by the American Society for Reproductive Medicine (ASRM) to disclose errors as soon as they are found. However, because the U.S. lacks mandatory federal reporting, many clinics manage these situations internally to avoid public litigation or reputational damage. In one documented case, a reproductive endocrinologist who concealed a mix-up faced a $1 million settlement and permanently lost his medical license.
Clinics will often offer to conduct genetic testing at their own expense following a discrepancy. While this may appear reassuring, it presents a significant conflict of interest. The clinic controls the samples, selects the laboratory, and manages the reporting process. An internally arranged test may also fail to meet the chain-of-custody standards required for legal proceedings, leaving you without admissible evidence if you later choose to pursue a negligence or breach of contract claim.
Why Independent DNA Testing Matters
To fully protect yourself and your family, independently verifying the fertility clinic’s claim the parent and child are biologically related. Allow families to ensures the laboratory with no ties to your fertility clinic. At IDTO DNA, our testing ensures your results are:
- Legally admissible — our chain-of-custody process is designed to hold up in IVF disputes and custody proceedings
- Unbiased — we provide a neutral, third-party audit of the clinic’s work
- Private — your results belong to you, not the clinic’s internal records
When a clinic offers free testing, they are managing their own legal risk. Independent testing is not an added cost it is an investment in your family’s legal rights.
